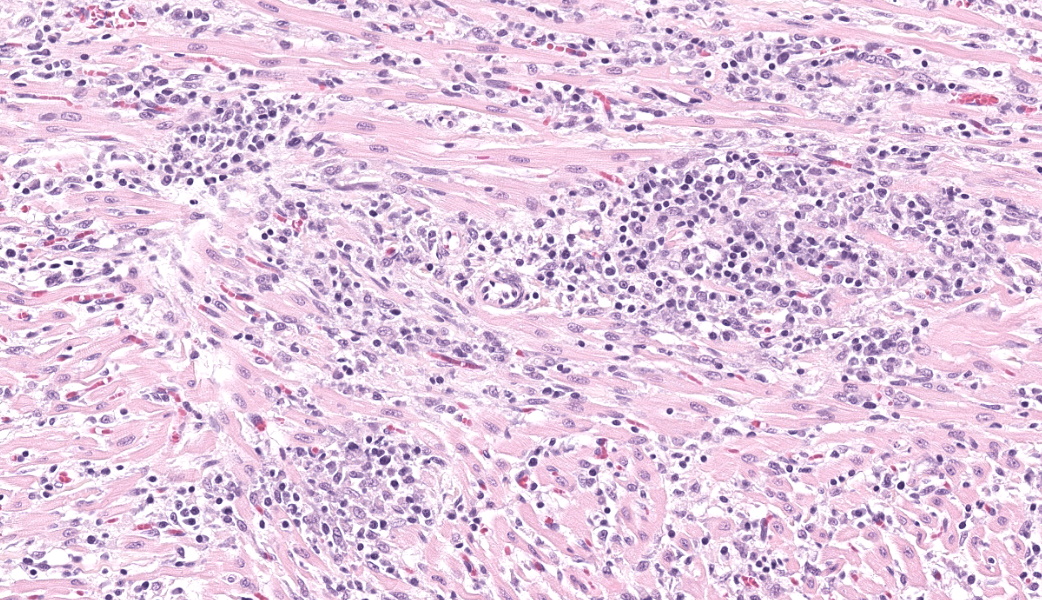

Wednesday Slide Conference, 2025-2026, Conference 5, Case 1
Signalment:
10-week-old, female intact, Mixed Breed, Canis lupus familiaris, Canine.History:
The submitted dog was from a litter of puppies that was found living underneath a shed in Texas. A rescue organization acquired the puppies, and the dog was later adopted by a family in Colorado. The dog was apparently healthy up until 10 weeks of age when she suddenly developed a bloated appearance and began vomiting. The animal's condition worsened overnight, becoming lethargic and not acting herself. The next morning, the dog went outside and tried to vomit but subsequently collapsed and died.Gross Pathology:
A 7.55 kg, intact female, mixed breed puppy was submitted for necropsy, one day postmortem, and in good condition. The lungs and heart were grossly unremarkable. The peritoneal cavity contained approximately 400 ml of serosanguinous fluid. All liver lobes had numerous, multifocal to coalescing, pinpoint, flat, tan foci that extended into the hepatic parenchyma on cut section. The stomach contained a black plastic clothing hook and yellow to green mucoid material. The small intestines contained yellow to tan liquid material and the large intestines had no intraluminal contents.Laboratory Results:
N/AMicroscopic Description:
Expanding and infiltrating all layers of the heart, with the greatest severity in the myocardium, are large numbers of plasma cells, lymphocytes, and macrophages. Cardiomyocytes in areas of inflammation are multifocally hypereosinophilic, shrunken, and have striation loss with fragmented to absent nuclei (necrosis). There is mild, multifocal, interstitial fibrosis often associated with cardiomyocyte degeneration and inflammation. Throughout the myocardium, there are occasional cardiomyocytes that contain intrasarcoplasmic, variably sized (up to 100 μm in length) pseudocysts with numerous, 2-3 μm, round protozoal amastigotes.Contributor's Morphologic Diagnoses:
Heart: Severe, multifocal, chronic-active, lymphoplasmacytic and histiocytic pancarditis with intrasarcoplasmic pseudocysts containing amastigotesContributor's Comment:
The histologic findings within the heart are most consistent with the protozoal organism, Trypanosoma cruzi, also known as Chagas disease or American trypanosomiasis. Trypanosoma cruzi is a flagellate protozoan organism that primarily harbors in an insect vector of the Triatominae family, most commonly the kissing bug or triatomine bug.5,8-10 It affects a variety of mammalian species across South, Central, and North America, including humans, domestic animals, and non-human primates.5,8-10 It is estimated that approximately 8 million people worldwide have this disease, and around 280,000 reside within the United States.5 Between 60 to 70% of people infected with T. cruzi will never develop clinical signs or symptoms, the remaining 30-40% will develop chronic symptomatic forms within 10 to 30 years.8The life cycle of T. cruzi is complex and begins when the triatomine bug feeds on a host’s blood infected with trypomastigotes. Once in the insect’s midgut, the trypomastigotes differentiate into the epimastigote form where they later become the infective metacyclic trypomastigotes at the rectal ampulla.5 The infective trypomastigotes are then excreted into the feces. As the now-infected bug moves on to its next victim, it will take a blood meal from the host and subsequently defecate near the bite wound. In humans, triatomine bugs will frequently bite along the face and near the mouth, hence their name “kissing bug”, due to their attraction to the carbon dioxide and warmth produced by the face. The parasites can then enter through the mucous membranes, the bite wound, or a cut/abrasion to the skin, as infected hosts will often scratch at the time of the bite. Once in the bloodstream, the metacyclic trypomastigotes will invade the host cells and begin the intracellular transition to amastigotes. Amastigotes will replicate by binary fission differentiating back to metacyclic trypomastigotes and rupturing the cell making their way back into the bloodstream.
T. cruzi can infect myocytes, endothelial cells, fibroblasts, and adipocytes, but has a tropism for cardiac muscle tissue.11 Grossly, there are no pathognomonic lesions for Chagas disease. Histologically, the cardiomyocytes will be expanded by a pseudocyst containing amastigotes. While best observed ultramicroscopically, the amastigotes will have a large nucleus and an adjacent rod-shaped kinetoplast, like Leishmania spp. Unlike the defined perpendicular orientation of the kinetoplast in Leishmania, the location of the kinetoplast relative to the nucleus changes during the life cycle and cannot be a diagnostic feature in Chagas disease.10 Unfortunately, additional diagnostics including PCR, culture, and serology were not performed so leishmaniasis cannot be completely ruled out, but the geographic and anatomic location of the organism along with the histologic appearance is most likely consistent with T. cruzi. Infection results in marked inflammation of the heart, often not associated with the intracellular pseudocysts. Myocarditis can lead to heart failure with cardiac arrest and potentially fatal arrhythmias. In this case, there was multi-organ evidence of heart failure including ascites (abdominal effusion) and centrilobular hepatocyte necrosis due to hypoxia.
Dogs play a crucial role in the domestic life cycle and are excellent reservoir hosts to continue parasite transmission. Cases have been reported in domestic and working dogs in South America and the southern United States, especially Texas and Gulf Coast states. Interestingly, the vectorial transmission that occurs in humans is less likely in dogs. Transmission is suspected to occur orally through ingestion of the infected vectors, ingestion of meat from infected mammals, or through ingestion of milk from infected lactating bitches.5,11 The human-companion animal relationship has become increasingly more important, and it is proposed that dogs could act as a sentinel for human exposure, environmental risks, and continued surveillance.5 Shelter and stray dogs with greater exposure to the outdoors are more likely to encounter T. cruzi and with increased human encroachment the interactions with wildlife reservoirs will also likely increase.3 There are no commercially available vaccines for dogs but potential vaccines are being tested including live-attenuated vaccines, recombinant protein and vector vaccines, and DNA and mRNA vaccines.3 Current prevention strategies include vector control methods and prophylactic treatment options.3
Contributing Institution:
Colorado State University Veterinary Diagnostic Laboratory https://vetmedbiosci.colostate.edu/vdl/JPC Diagnoses:
Heart: Pancarditis, lymphoplasmacytic and histiocytic, subacute, multifocal to coalescing, marked, with numerous sarcoplasmic amastigotes.JPC Comment:
Moderated by MAJ William Baskerville, the 5th WSC of the year started off with a great case of a relevant infectious disease that is gathering more attention as it spreads within the United States: American trypanosomiasis (Chagas disease). Chagas disease was recently designated as endemic in the southern United States.5 Current data also indicate that, as temperatures continue to trend warmer, the triatome vectors of Chagas are increasing and expanding their range further north in the United States. Conference discussion largely centered on this being a growing health concern within the US for both humans and veterinary species, especially domestic dogs that are housed outdoors in kennel situations and have higher rates of exposure to insect vectors. This has been exceptionally relevant for military working dogs (MWDs) housed in Texas kennels, where there has been a disproportionally high number of MWDs contracting Chagas Disease compared to other locations within the US. Due to the likelihood of contact with vectors in these housing situations, dogs are currently being looked at as a sentinel species for this condition.The causative protozoa’s tropism for specific tissues can result in fatal chronic disease in the heart, esophagus, and/or colon.6 While most infections are asymptomatic, in humans, approximately 30% of chronically infected people will develop cardiomyopathy, megacolon, or megaesophagus with chronic Chagas disease.5 In fact, this condition is the current leading cause of infectious myocarditis in humans and most robust blood-banking operations are now testing for Trypanosoma cruzi before administering blood to patients. Trypomastigotes of T. cruzi detect and subsequently alter their movement in the presence of mammalian cells and, in the presence of specific cell types, will respond more strongly to and invade these cells over alternative cell lineages.2
Across multiple studies, it has been demonstrated that T. cruzi shows particular tropism for cardiomyocytes.1,2,6,13 Studies in rats have demonstrated that cardiomyocytes infected with T. cruzi lose their gap junctional communication, which results in decreased automaticity of the cardiac muscle with subsequent electrical alterations.7 Gap junction proteins (connexins) enable transmission of ions and signaling molecules between cells, making them critical to proper cardiac function.6 Similarly, mouse cardiac myocytes infected with T. cruzi trypomastigotes had significant alterations in connexin43 (Cx43) distribution with an initial increase in their expression in peracute infection followed by a marked decrease in acute and chronic infections. These gap junction disruptions are thought to contribute to the heart’s electrical dysregulation observed in some T. cruzi infections.1
It has also been suggested that T. cruzi exploits a HIF-1α-dependent, stress-related activation of glycolysis that is intrinsic to cardiomyocytes, further promoting intracellular infection and replication.15 These chronic stress responses by cardiomyocytes lead to dysfunction, cell death, and, ultimately, development of cardiac disease. More recently, in vitro studies have demonstrated possible cell-to-cell transfer of the parasite between cardiomyocytes, although the mechanism by which this occurs is not yet known.5
Along with exploiting cellular pathways, T. cruzi also utilizes a handful of virulence factors to invade host cells, including a trans-sialidase to allow the parasite to bind to host cells, a penetrin to mediate invasion into a host cell, neuraminidase and hemolysins to destabilize and disrupt lysosomes, and galectin-3 (gal-3).10 Gal-3 in particular is being studied as a potential target for therapeutics, as it is involved in the stimulation of cardiac fibroblasts to synthesize Type I collagen and resultant cardiac fibrosis. One study found, in vivo, that mice infected with T. cruzi that were subsequently treated with a gal-3 blocker had significantly reduced cardiac fibrosis and inflammation.10 With this disease on the rise in the Southern U.S. and South American nations, the growing body of research on Chagas disease will become ever more important as scientists and medical professionals attempt to further the development of treatments and preventatives for this condition.
References:
- Adesse D, Garzoni LR, Huang H, Tanowitz HB, de Nazareth Meirelles M, Spray DC. Trypanosoma cruzi induces changes in cardiac connexin43 expression. Microbes Infect. 2008;10(1):21-8.
- Arias-Del-Angel JA, Santana-Solano J, Santillán M, Manning-Cela RG. Motility patterns of Trypanosoma cruzi trypomastigotes correlate with the efficiency of parasite invasion in vitro. Sci Rep. 2020;10(1):15894.
- Barr SC. Canine Chagas’ Disease (American Trypanosomiasis) in North America. Veterinary Clinics: Small Animal Practice. 2009;39(6):1055-1064.
- Busselman RE, Meyers AC, Zecca IB, et al. High incidence of Trypanosoma cruzi infections in dogs directly detected through longitudinal tracking at 10 multi-dog kennels, Texas, USA. PLoS Negl Trop Dis. 2021;15(11):e0009935.
- About Chagas Disease. Chagas Disease. September 4, 2024. Accessed June 16, 2025. https://www.cdc.gov/chagas/about/index.html.
- Contreras-Ortiz JME, Hernández-Mendoza D, Márquez-Dueñas C, Manning-Cela R, Santillán M. In vitro characterization of Trypanosoma cruzi infection dynamics in skeletal and cardiac myotubes models suggests a potential cell-to-cell transmission in mediating cardiac pathology. PLoS Negl Trop Dis. 2024;18(6):e0012288.
- de Carvalho AC, Tanowitz HB, Wittner M, Dermietzel R, Roy C, Hertzberg EL, Spray DC. Gap junction distribution is altered between cardiac myocytes infected with Trypanosoma cruzi. Circ Res. 1992;70(4):733-42.
- Durães-Oliveira J, Palma-Marques J, Moreno C, et al. Chagas Disease: A Silent Threat for Dogs and Humans. International Journal of Molecular Sciences. 2024;25(7):3840.
- Sousa AS de, Vermeij D, Ramos AN, Luquetti AO. Chagas disease. The Lancet. 2024;403(10422):203-218.
- Souza BSF, Silva DN, Carvalho RH, Sampaio GLA, Paredes BD, Aragão França L, Azevedo CM, Vasconcelos JF, Meira CS, Neto PC, Macambira SG, da Silva KN, Allahdadi KJ, Tavora F, de Souza Neto JD, Dos Santos RR, Soares MBP. Association of Cardiac Galectin-3 Expression, Myocarditis, and Fibrosis in Chronic Chagas Disease Cardiomyopathy. Am J Pathol. 2017;187(5):1134-1146.
- Rassi A, Marin-Neto JA. Chagas disease. The Lancet. 2010;375(9723):1388-1402.
- Hodo CL, Wilkerson GK, Birkner EC, Gray SB, Hamer SA. Trypanosoma cruzi Transmission Among Captive Nonhuman Primates, Wildlife, and Vectors. Ecohealth. 2018;15(2):426-436.
- Montalvo-Ocotoxtle IG, Rojas-Velasco G, Rodríguez-Morales O, et al. Chagas Heart Disease: Beyond a Single Complication, from Asymptomatic Disease to Heart Failure. Journal of Clinical Medicine. 2022;11(24):7262.
- Teixeira ARL, Hecht MM, Guimaro MC, Sousa AO, Nitz N. Pathogenesis of Chagas’ Disease: Parasite Persistence and Autoimmunity. Clin Microbiol Rev. 2011;24(3):592-630.
- Venturini G, Alvim JM, Padilha K, Toepfer CN, Gorham JM, Wasson LK, Biagi D, Schenkman S, Carvalho VM, Salgueiro JS, Cardozo KHM, Krieger JE, Pereira AC, Seidman JG, Seidman CE. Cardiomyocyte infection by Trypanosoma cruzi promotes innate immune response and glycolysis activation. Front Cell Infect Microbiol. 2023;13:1098457.